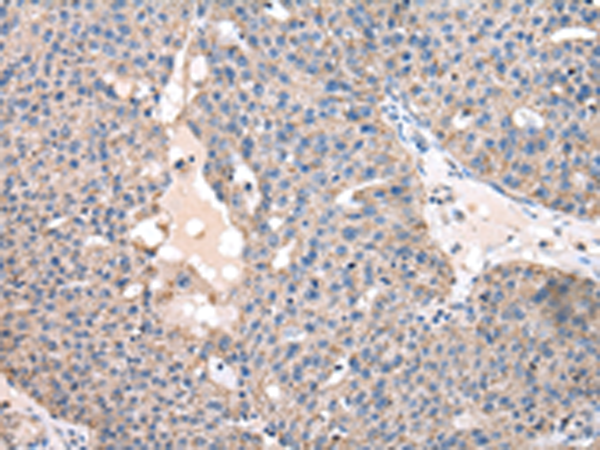
一抗

Background:
Substrate-specific adapter for the anaphase promoting complex/cyclosome (APC/C) E3 ubiquitin-protein ligase complex. Associates with the APC/C in late mitosis, in replacement of CDC20, and activates the APC/C during anaphase and telophase. The APC/C remains active in degrading substrates to ensure that positive regulators of the cell cycle do not accumulate prematurely. At the G1/S transition FZR1 is phosphorylated, leading to its dissociation from the APC/C. Following DNA damage, it is required for the G2 DNA damage checkpoint: its dephosphorylation and reassociation with the APC/C leads to the ubiquitination of PLK1, preventing entry into mitosis. Acts as an adapter for APC/C to target the DNA-end resection factor RBBP8/CtIP for ubiquitination and subsequent proteasomal degradation. Through the regulation of RBBP8/CtIP protein turnover, may play a role in DNA damage response, favoring DNA double-strand repair through error-prone non-homologous end joining (NHEJ) over error-free, RBBP8-mediated homologous recombination (HR) (PubMed:25349192).
Applications:
WB, IHC
Name of antibody:
FZR1
Immunogen:
Fusion protein of human FZR1
Full name:
fizzy and cell division cycle 20 related 1
Synonyms:
FZR; CDH1; FZR2; HCDH; HCDH1; CDC20C
SwissProt:
Q9UM11
IHC positive control:
Human breast cancer and Human esophagus cancer
IHC Recommend dilution:
25-100
WB Predicted band size:
55 kDa
WB Positive control:
Human placenta tissue
WB Recommended dilution:
500-2000


 購物車
購物車 幫助
幫助
 021-54845833/15800441009
021-54845833/15800441009